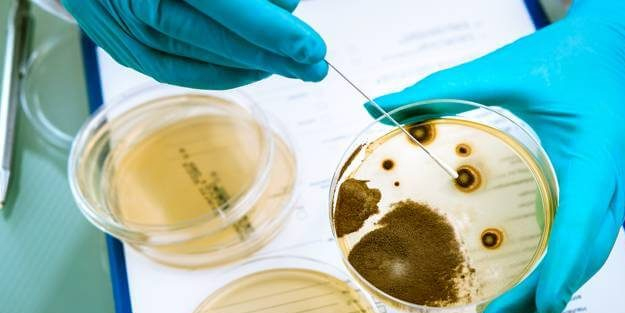
6 çeşit peynirde listeria bakterisi tespit edildi! Listeria nedir, belirtileri nelerdir?

İnsanlığın en eski tatlısı aşure! Aşure tarifi nasıl yapılır?

Türk mutfağının simge tatlılarından aşure, İngiliz yayın kuruluşu BBC'ye konu oldu. Haberde aşure için, “İnsanlığın en eski tatlısı" denildi. Tatlının Türk tarihi için önemine vurgu yapıldı.
Hem yüksek besin değerine sahip, hem de Türk geleneğinin vazgeçilmez tatlılarından. Aşure, bu kez BBC sayfalarında. İngiliz medya devi BBC, binlerce yıllık geleneğe sahip aşure tatlısından, insanlık tarihinin en eski tatlısı olarak bahsetti.
BBC haberinde, aşurenin tarihine de değindi. Tatlının, Nuh Tufanı’na dayandığı, yapımında kullanılan malzemelerin sağlıklı ve doyurucu olduğu vurgulandı. Aşurenin, Arapça ‘da 10 anlamına geldiği ve hicri takvimin ilk ayı olan muharrem ayının 10’uncu gününü ifade ettiği ve Alevilik inancında önemli bir yeri olduğu bilgisi paylaşıldı.
Anadolu’daki çok kültürlü yapının önemli simgelerinden biri olduğu da eklendi.
Aşure tarifi nasıl yapılır?
Aşure tarifi için malzemeler
- (15 Kaselik)
- 2 su bardağı aşurelik buğday
- 2 yemek kaşığı pirinç
- 2 su bardağı haşlanmış nohut
- 2 su bardağı haşlanmış fasulye
- 150 gram kuru kayısı
- 150 gram kuru incir
- 150 gram kuru üzüm
- 1 su bardağından biraz az fındık
- 2 litre su (buğdayları pişirmek için)
- 4 litre sıcak su (su azaldıkça eklemek için)
- 1 tatlı kaşığı karanfil
- 1 çay bardağı su (karanfili kaynatmak için)
- 1,5 su bardağı sıcak süt
- 3 su bardağı toz şeker
- 1 fiske tuz
- 1 fiske karabiber
İnsanlığın en eski tatlısı aşure! Aşure tarifi nasıl yapılır?
İlk olarak nohut ve fasulyeyi ayrı ayrı haşlayalım. Buğdayı yıkayıp, tencereye alalım, üzerine kaynar su ekleyip 10 dk kaynatalım. Çıkan sarı suyu süzelim. Aynı işlemi bir kez daha yapalım ve suyunu süzelim. Daha sonra üzerine 2 litre kadar su ekleyip, 50 dk kadar buğdayı kaynatalım. (Dilerseniz akşamdan iki kez kaynatıp, suyunu süzerek daha sonra sıcak suda sabaha kadar bekletebilirsiniz. Akşamdan ıslatırsanız, 15 dk kaynatmak yeterli olacaktır.). Kuru kayısı ve kuru inciri küçük küçük doğrayalım.
Ardından doğradığımız bu meyveleri ve kuru üzümü geniş bir kaseye alarak üzerine sıcak su ekleyelim ve bekletelim. Arada gerektikçe sıcak su eklemeyi ihmal etmeyin. Suyu azalan buğdaylarımıza biraz daha sıcak su ekleyelim. Yaklaşık 50 dakika kadar kaynattığımız ve yumuşayan buğdaya yıkanmış pirinç, pişmiş nohut, haşlanmış fasulye, küçük doğranmış kayısı, incir ve kuru üzümünde suyunu süzerek ekleyelim ve 15 dk kadar kaynatalım. Küçük bir cezve içerisine karanfil alalım ve suyu da ekleyerek 10 dakika kadar kaynamaya bırakalım. Bu sırada suyu azalan buğdaylarımızın üzerine tekrar sıcak su ilave edelim.
Son olarak süzgeçten geçirdiğimiz karanfil suyu, fındık, sıcak süt, şeker, isteğe bağlı tuz, karabiber ekleyerek karıştıralım ve yaklaşık 15-20 dk daha kaynatalım.
Hazırladığımız aşuremizi tek tek cam kaselere bölüştürelim. Biz bu ölçüler ile 15 kase aşure elde ettik.
Aşure kaselerde soğumaya yüz tutunca, üzerini fındık, ceviz, fıstık, kuş üzümü, kuru üzüm ve nar taneleri ile süsleyebilirsiniz. Afiyet olsun.